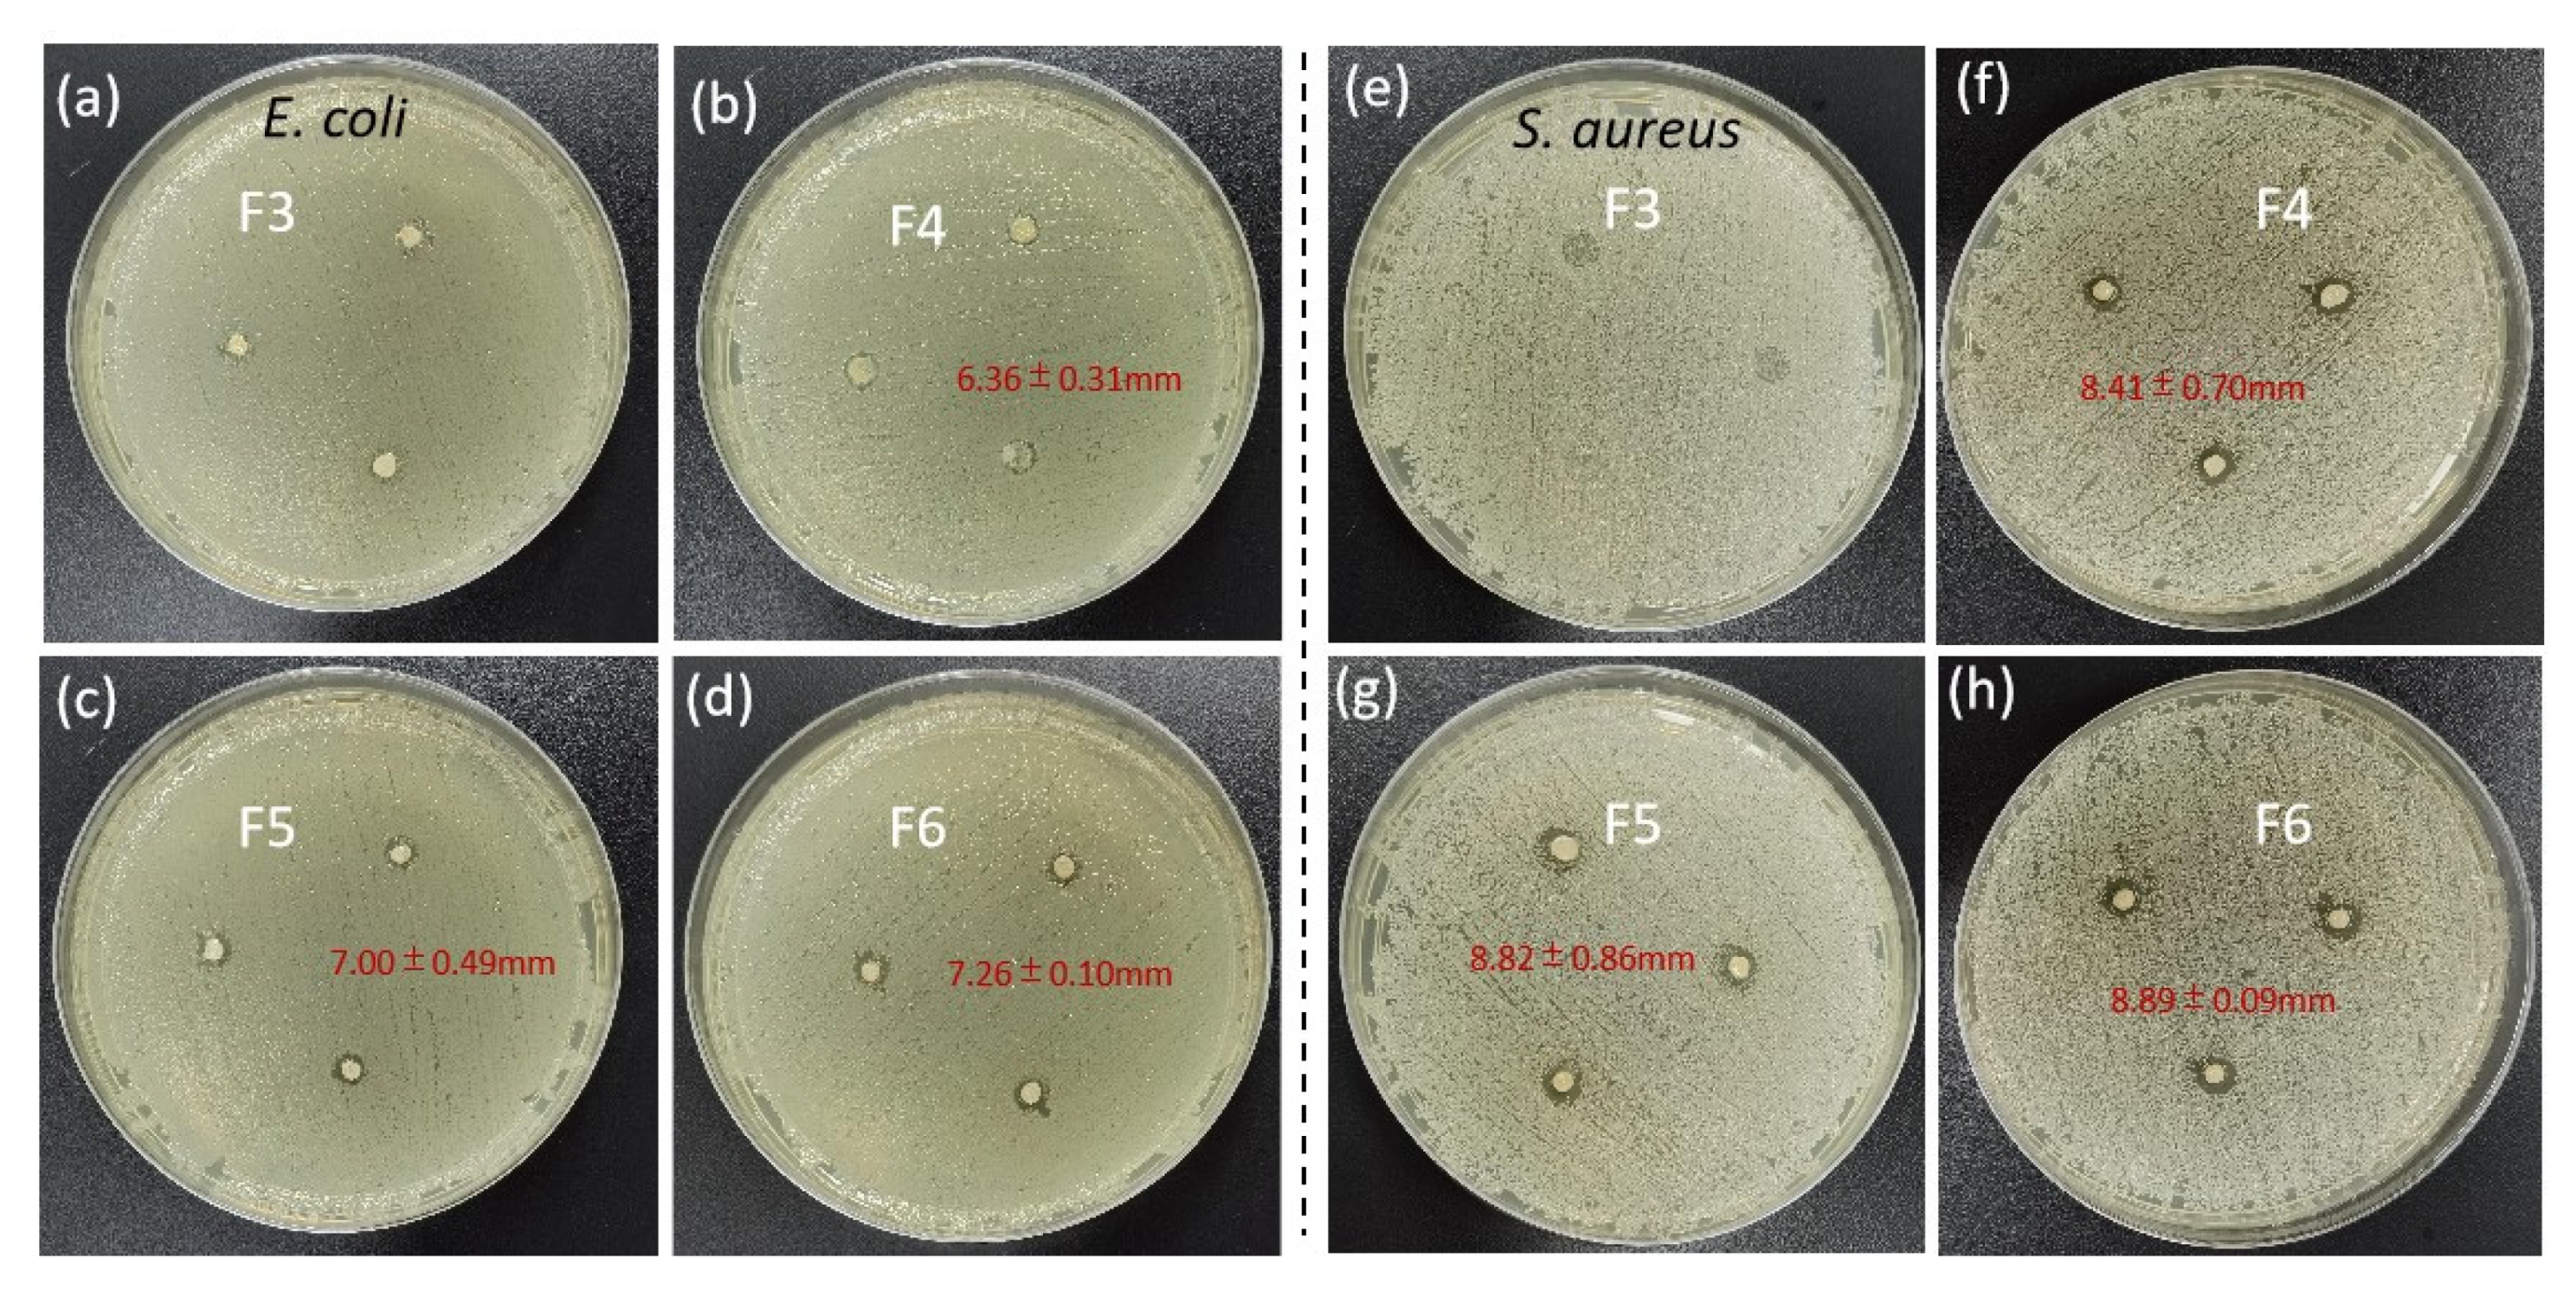
Biomolecules 12 01110 g009

Electrospun Zein/Polyoxyethylene Core-Sheath Ultrathin Fibers and Their Antibacterial Food Packaging Applications
Abstract
:1. Introduction
2. Materials and Methods
2.1. Materials
2.2. Electrospinning Preparation Process
2.3. Morphology and Structure
2.4. Physical Status and Compatibility
2.5. Water Contact Angle
2.6. Release Behavior
2.7. Antibacterial Activity
2.8. Application to Cherry Tomato Packaging
2.9. Statistical Analysis
3. Results and Discussion
3.1. Coaxial Electrospinning Process
3.2. Morphology and Structure of Core-Sheath Ultrathin Fibers
3.3. Physical State and Compatibility of Core-Sheath Ultrathin Fibers
3.4. Surface Water Contact Property of Functional Ultrathin Fibers
3.5. Release Behavior of Resveratrol from Functional Ultrathin Fibers
3.6. Antibacterial Activity of Functional Nanofibers
3.7. Practical Application of Packaging Cherry Tomatoes
4. Conclusions
Author Contributions
Funding
Institutional Review Board Statement
Informed Consent Statement
Data Availability Statement
Conflicts of Interest
References
- Sid, S.; Mor, R.S.; Kishore, A.; Sharanagat, V.S. Bio-sourced polymers as alternatives to conventional food packaging materials: A review. Trends Food Sci. Tech. 2021, 115, 87–104. [Google Scholar] [CrossRef]
- Atta, O.M.; Manan, S.; Shahzad, A.; Ul-Islam, M.; Ullah, M.W.; Yang, G. Biobased materials for active food packaging: A review. Food Hydrocolloid. 2022, 125, 107419. [Google Scholar] [CrossRef]
- Zhang, Y.; Li, S.; Xu, Y.; Shi, X.; Zhang, M.; Huang, Y.; Liang, Y.; Chen, Y.; Ji, W.; Kim, J.R.; et al. Engineering of hollow polymeric nanosphere-supported imidazolium-based ionic liquids with enhanced antimicrobial activities. Nano Res. 2022, 15, 5556–5568. [Google Scholar] [CrossRef]
- Lozano-Navarro, J.I.; Diaz-Zavala, N.P.; Velasco-Santos, C.; Martinez-Hernandez, A.L.; Tijerina-Ramos, B.I.; Garcia-Hernandez, M.; Rivera-Armenta, J.L.; Paramo-Garcia, U.; Reyes-de la Torre, A.I. Antimicrobial, optical and mechanical properties of chitosan-starch films with natural extracts. Int. J. Mol. Sci. 2017, 18, 997. [Google Scholar] [CrossRef]
- Aminzare, M.; Moniri, R.; Hassanzad Azar, H.; Mehrasbi, M.R. Evaluation of antioxidant and antibacterial interactions between resveratrol and eugenol in carboxymethyl cellulose biodegradable film. Food Sci. Nutr. 2021, 10, 155–168. [Google Scholar] [CrossRef] [PubMed]
- Teixeira-Costa, B.E.; Andrade, C.T. Chitosan as a valuable biomolecule from seafood industry waste in the design of green food packaging. Biomolecules 2021, 11, 1599. [Google Scholar] [CrossRef]
- Al-Hashimi, N.; Babenko, M.; Saaed, M.; Kargar, N.; ElShaer, A. The impact of natural and synthetic polymers in formulating micro and nanoparticles for anti-diabetic drugs. Curr. Drug Deliv. 2021, 18, 271–288. [Google Scholar] [CrossRef]
- Zhang, C.; Li, Y.; Wang, P.; Zhang, H. Electrospinning of nanofibers: Potentials and perspectives for active food packaging. Compr. Rev. Food Sci. F 2020, 19, 479–502. [Google Scholar] [CrossRef]
- Charles, A.P.R.; Jin, T.Z.; Mu, R.; Wu, Y. Electrohydrodynamic processing of natural polymers for active food packaging: A comprehensive review. Compr. Rev. Food Sci. F 2021, 20, 6027–6056. [Google Scholar] [CrossRef]
- Lv, H.; Guo, S.; Zhang, G.; He, W.; Wu, Y.; Yu, D.G. Electrospun structural hybrids of acyclovir-polyacrylonitrile at acyclovir for modifying drug release. Polymers 2021, 13, 4286. [Google Scholar] [CrossRef]
- Krysiak, Z.J.; Stachewicz, U. Electrospun fibers as carriers for topical drug delivery and release in skin bandages and patches for atopic dermatitis treatment. Wires. Nanomed. Nanobiotechnol. 2022, 14, e1829. [Google Scholar] [CrossRef] [PubMed]
- Jiang, W.L.; Du, Y.T.; Ji, Y.X.; Zhou, Y.Q.; Zhao, P.; Yu, D.G. Modernization of traditional Chinese condiments via electrospun polymeric nanocomposites. ES Food Agrofor. 2022, 8, 47–56. [Google Scholar] [CrossRef]
- Kang, S.; Hou, S.; Chen, X.; Yu, D.G.; Wang, L.; Li, X.; Williams, G.R. Energy-saving electrospinning with a concentric teflon-core rod spinneret to create medicated nanofibers. Polymers 2020, 12, e2421. [Google Scholar] [CrossRef] [PubMed]
- Farkas, B.; Balogh, A.; Cselko, R.; Molnar, K.; Farkas, A.; Borbas, E.; Marosi, G.; Nagy, Z.K. Corona alternating current electrospinning: A combined approach for increasing the productivity of electrospinning. Int. J. Pharm. 2019, 561, 219–227. [Google Scholar] [CrossRef] [PubMed]
- Maria Leena, M.; Yoha, K.S.; Moses, J.A.; Anandharamakrishnan, C. Edible coating with resveratrol loaded electrospun zein nanofibers with enhanced bioaccessibility. Food Biosci. 2020, 36, 100669. [Google Scholar] [CrossRef]
- Basavegowda, N.; Baek, K.H. Synergistic antioxidant and antibacterial advantages of essential oils for food packaging applications. Biomolecules 2021, 11, 1267. [Google Scholar] [CrossRef] [PubMed]
- Sivan, M.; Madheswaran, D.; Valtera, J.; Kostakova, E.K.; Lukas, D. Alternating current electrospinning: The impacts of various high-voltage signal shapes and frequencies on the spinnability and productivity of polycaprolactone nanofibers. Mater. Des. 2022, 213, 110308. [Google Scholar] [CrossRef]
- Zelko, R.; Lamprou, D.A.; Sebe, I. Recent Development of Electrospinning for drug delivery. Pharmaceutics 2019, 12, 5. [Google Scholar] [CrossRef]
- Yu, D.G.; Lv, H. Preface-striding into nano drug delivery. Curr. Drug Deliv. 2022, 19, 1–3. [Google Scholar] [CrossRef]
- Zhao, K.; Lu, Z.H.; Zhao, P.; Kang, S.X.; Yang, Y.Y.; Yu, D.G. Modified tri–axial electrospun functional core–shell nanofibrous membranes for natural photodegradation of antibiotics. Chem. Eng. J. 2021, 425, 131455. [Google Scholar] [CrossRef]
- Guo, S.; Jiang, W.; Shen, L.; Zhang, G.; Gao, Y.; Yang, Y.; Yu, D.G. Electrospun hybrid films for fast and convenient delivery of active herb extracts. Membranes 2022, 12, 398. [Google Scholar] [CrossRef] [PubMed]
- Xu, L.; Liu, Y.; Zhou, W.; Yu, D. Electrospun medical sutures for wound healing: A review. Polymers 2022, 14, 1637. [Google Scholar] [CrossRef] [PubMed]
- Brimo, N.; Serdaroğlu, D.Ç.; Uysal, B. Comparing antibiotic pastes with electrospun nanofibers as modern drug delivery systems for regenerative endodontics. Curr. Drug Deliv. 2022, 19, 904–917. [Google Scholar] [CrossRef] [PubMed]
- Brimo, N.; Serdaroğlu, D.Ç.; Uyar, T.; Uysal, B.; Çakıcı, E.B.; Dikmen, M.; Canturk, Z. Novel electrospun polymeric nanofibers loaded different medicaments as drug delivery systems for regenerative endodontics. Curr. Drug Deliv. 2022, 19, 1–11. [Google Scholar] [CrossRef]
- Yao, Z.-C.; Chang, M.W.; Ahmad, Z.; Li, J.S. Encapsulation of rose hip seed oil into fibrous zein films for ambient and on demand food preservation via coaxial electrospinning. J. Food Eng. 2016, 191, 115–123. [Google Scholar] [CrossRef]
- Liu, X.; Zhang, M.; Song, W.; Zhang, Y.; Yu, D.-G.; Liu, Y. Electrospun core (HPMC-acetaminophen)-shell (PVP-sucralose) nanohybrids as orodispersible drug delivery devices. Gels 2022, 8, 357. [Google Scholar] [CrossRef]
- Liu, Y.B.; Chen, X.H.; Yu, D.G.; Liu, H.; Liu, Y.Y.; Liu, P. Electrospun PVP-core/PHBV-shell fibers to eliminate tailing off for an improved sustained release of curcumin. Mol. Pharm. 2021, 18, 4170–4178. [Google Scholar] [CrossRef]
- Yang, H.; Feng, K.; Wen, P.; Zong, M.H.; Lou, W.Y.; Wu, H. Enhancing oxidative stability of encapsulated fish oil by incorporation of ferulic acid into electrospun zein mat. LWT- Food Sci.Technol. 2017, 84, 82–90. [Google Scholar] [CrossRef]
- Ning, T.; Zhou, Y.; Xu, H.-X.; Guo, S.; Yu, D.-G. Orodispersible membranes from a modified coaxial electrospinning for fast dissolution of diclofenac sodium. Membranes 2021, 11, 802. [Google Scholar] [CrossRef]
- Liu, Y.; Chen, X.; Gao, Y.; Yu, D.G.; Liu, P. Elaborate design of shell component for manipulating the sustained release behavior from core–shell nanofibres. J. Nanobiotechnol. 2022, 20, 244. [Google Scholar] [CrossRef]
- Zhou, Y.; Liu, Y.; Zhang, M.; Feng, Z.; Yu, D.G.; Wang, K. Electrospun nanofiber membranes for air filtration: A review. Nanomaterials 2022, 12, 1077. [Google Scholar] [CrossRef] [PubMed]
- Han, D.; Sherman, S.; Filocamo, S.; Steckl, A.J. Long-term antimicrobial effect of nisin released from electrospun triaxial fiber membranes. Acta Biomater. 2017, 53, 242–249. [Google Scholar] [CrossRef] [PubMed]
- Liu, H.; Wang, H.; Lu, X.; Murugadoss, V.; Huang, M.; Yang, H.; Wan, F.; Yu, D.G.; Guo, Z. Electrospun structural nanohybrids combining three composites for fast helicide delivery. Adv. Compos.Hybrid Mater. 2022, 5, 1017–1029. [Google Scholar] [CrossRef]
- Zhan, L.; Deng, J.; Ke, Q.; Li, X.; Ouyang, Y.; Huang, C.; Liu, X.; Qian, Y. Grooved fibers: Preparation principles through electrospinning and potential applications. Adv. Fiber Mater. 2022, 4, 203–213. [Google Scholar] [CrossRef]
- Zhang, Y.; Song, W.; Lu, Y.; Xu, Y.; Wang, C.; Yu, D.G.; Kim, I. Recent Advances in poly(α-L-glutamic acid)-based nanomaterials for drug delivery. Biomolecules 2022, 12, 636. [Google Scholar] [CrossRef] [PubMed]
- Yu, D.G.; Wang, M.; Ge, R. Strategies for sustained drug release from electrospun multi-layer nanostructures. Wires. Nanomed. Nanobi. 2021, 14, e1772. [Google Scholar] [CrossRef]
- Zhang, X.; Guo, S.; Qin, Y.; Li, C. Functional electrospun nanocomposites for efficient oxygen reduction reaction. Chem. Res. Chin. Univ. 2021, 37, 379–393. [Google Scholar]
- Han, Y.; Ding, J.; Zhang, J.; Li, Q.; Yang, H.; Sun, T.; Li, H. Fabrication and characterization of polylactic acid coaxial antibacterial nanofibers embedded with cinnamaldehyde/tea polyphenol with food packaging potential. Int. J. Biol. Macromol. 2021, 184, 739–749. [Google Scholar]
- Patiño Vidal, C.; Velásquez, E.; Galotto, M.J.; López de Dicastillo, C. Development of an antibacterial coaxial bionanocomposite based on electrospun core/shell fibers loaded with ethyl lauroyl arginate and cellulose nanocrystals for active food packaging. Food Packag. Shelf. 2022, 31, 100802. [Google Scholar] [CrossRef]
- Aman mohammadi, M.; Ramazani, S.; Rostami, M.; Raeisi, M.; Tabibiazar, M.; Ghorbani, M. Fabrication of food-grade nanofibers of whey protein Isolate–Guar gum using the electrospinning method. Food Hydrocolloid. 2019, 90, 99–104. [Google Scholar] [CrossRef]
- Yang, W.; Zhang, M.; Li, X.; Jiang, J.; Sousa, A.M.M.; Zhao, Q.; Pontious, S.; Liu, L. Incorporation of tannic acid in food-grade guar gum fibrous mats by electrospinning technique. Polymers 2019, 11, 141. [Google Scholar] [CrossRef] [PubMed]
- Tang, Y.; Varyambath, A.; Ding, Y.; Chen, B.; Huang, X.; Zhang, Y.; Yu, D.G.; Kim, I.; Song, W. Porous organic polymers for drug delivery: Hierarchical pore structures, variable morphologies, and biological properties. Biomater. Sci. 2022. [CrossRef] [PubMed]
- Xu, X.Z.; Lv, H.; Zhang, M.X.; Wang, M.L.; Zhou, Y.J.; Liu, Y.N.; Yu, D.G. Progress on electrospun nanofiber for heavy metal wastewater applications: A review. Front. Chem. Sci. Eng. 2022, 16, 1–17. [Google Scholar]
- Mendes, A.C.; Stephansen, K.; Chronakis, I.S. Electrospinning of food proteins and polysaccharides. Food Hydrocolloid. 2017, 68, 53–68. [Google Scholar] [CrossRef]
- Castro, C.S.; Nogueiro, E.B.; Rocha, F. Encapsulation in food industry with emerging electrohydrodynamic techniques: Electrospinning and electrospraying-A review. Food Chem. 2021, 339, 127850. [Google Scholar] [CrossRef]
- Glusac, J.; Fishman, A. Enzymatic and chemical modification of zein for food application. Trends Food Sci. Tech. 2021, 112, 507–517. [Google Scholar] [CrossRef]
- Altan, A.; Aytac, Z.; Uyar, T. Carvacrol loaded electrospun fibrous films from zein and poly(lactic acid) for active food packaging. Food Hydrocolloid. 2018, 81, 48–59. [Google Scholar] [CrossRef]
- Hirsch, E.; Pantea, E.; Vass, P.; Domján, J.; Molnár, M.; Suhajda, Á.; Andersen, S.K.; Vigh, T.; Verreck, G.; Marosi, G.J.; et al. Probiotic bacteria stabilized in orally dissolving nanofibers prepared by high-speed electrospinning. Food Bioprod. Process. 2021, 128, 84–94. [Google Scholar] [CrossRef]
- Khalid, G.M.; Selmin, F.; Musazzi, U.M.; Gennari, C.G.M.; Minghetti, P.; Cilurzo, F. Trends in the characterization methods of orodispersible films. Curr. Drug. Deliv. 2021, 18, 941–952. [Google Scholar] [CrossRef]
- Eab, K.; Kab, M.; Pc, B.; Ac, T.S.; Ia, J.C.R. Biocompatible silver nanoparticles/poly(vinyl alcohol) electrospun nanofibers for potential antimicrobial food packaging applications. Food Packaging Shelf. 2019, 21, 100379. [Google Scholar]
- Mofidfar, M.; Kim, E.S.; Larkin, E.L.; Long, L.; Jennings, W.D.; Ahadian, S.; Ghannoum, M.A.; Wnek, G.E. Antimicrobial activity of silver containing crosslinked Poly(acrylic acid) fibers. Micromachines 2019, 10, 829. [Google Scholar] [CrossRef] [PubMed]
- Aktürk, A.; Erol Taygun, M.; Karbancıoğlu Güler, F.; Goller, G.; Küçükbayrak, S. Fabrication of antibacterial polyvinylalcohol nanocomposite mats with soluble starch coated silver nanoparticles. Colloid. Surf. A 2019, 562, 255–262. [Google Scholar] [CrossRef]
- Valipour Motlagh, N.; Aghazamani, J.; Gholami, R. Investigating the effect of nano-silver contained packaging on the olivier salad shelf-life. BioNanoScience 2021, 11, 838–847. [Google Scholar] [CrossRef]
- Marrez, D.A.; Abdelhamid, A.E.; Darwesh, O.M. Eco-friendly cellulose acetate green synthesized silver nano-composite as antibacterial packaging system for food safety. Food Packag. Shelf. 2019, 20, 100302. [Google Scholar] [CrossRef]
- Wang, Y.; Jia, S.; Luo, W.; Meng, L.; Wang, B.; Meng, X.; Liu, J.; Zhong, H.; Shao, Z. Inch-sized aligned polymer nanofiber films with embedded CH3NH3PbBr3 nanocrystals: Electrospinning fabrication using a folded aluminum foil as the collector. Nanotechnology 2020, 31, 075708. [Google Scholar] [CrossRef]
- Huang, C.; Xu, X.; Fu, J.; Yu, D.-G.; Liu, Y. Recent Progress in Electrospun Polyacrylonitrile Nanofifiber-Based Wound Dressing. Polymers 2022, 14, 3266. [Google Scholar] [CrossRef]
- Yu, D.G. Preface—Bettering drug delivery knowledge from pharmaceutical techniques and excipients. Curr. Drug Deliv. 2021, 18, 2–3. [Google Scholar] [CrossRef]
- Liu, Y.; Chen, X.; Gao, Y.; Liu, Y.; Yu, D.; Liu, P. Electrospun Core–Sheath Nanofibers with Variable Shell Thickness for Modifying Curcumin Release to Achieve a Better Antibacterial Performance. Biomolecules 2022, 12, 1057. [Google Scholar] [CrossRef]
- Wang, M.L.; Yu, D.G.; Williams, G.R.; Bligh, S.W.A. Co-loading of inorganic nanoparticles and natural oil in the Electrospun Janus nanofibers for a synergetic antibacterial effect. Pharmaceutics 2022, 14, 1208. [Google Scholar] [CrossRef]
- Liu, Y.; Lv, H.; Liu, Y.; Gao, Y.; Kim, H.Y.; Ouyang, Y.; Yu, D.G. Progresses on electrospun metal–organic frameworks nanofibers and their wastewater treatment applications. Mate. Today Chem. 2022, 25, 100974. [Google Scholar] [CrossRef]
- Xu, X.; Zhang, M.; Lv, H.; Yang, Y.; Yu, D.G. Electrospun polyacrylonitrile-based lace nanostructures and their Cu(II) adsorption. Sep. Purif. Technol. 2022, 288, 120643. [Google Scholar] [CrossRef]
- Lv, H.; Zhang, M.X.; Wang, P.; Xu, X.Z.; Liu, Y.N.; Yu, D.G. Ingenious construction of Ni(DMG)2/TiO2-decorated porous nanofibers for the highly efficient photodegradation of pollutants in water. Colloid Surf. A 2022, 650, 129561. [Google Scholar] [CrossRef]
- Wen, P.; Zhu, D.H.; Wu, H.; Zong, M.H.; Jing, Y.R.; Han, S.Y. Encapsulation of cinnamon essential oil in electrospun nanofibrous film for active food packaging. Food Control 2016, 59, 366–376. [Google Scholar] [CrossRef]
- Huang, C.; Dong, J.; Zhang, Y.; Chai, S.; Wang, X.; Kang, S.; Yu, D.; Wang, P.; Jiang, Q. Gold nanoparticles-loaded polyvinylpyrrolidone/ethylcellulose coaxial electrospun nanofibers with enhanced osteogenic capability for bone tissue regeneration. Mater. Des. 2021, 212, 110240. [Google Scholar] [CrossRef]
- Ghazalian, M.; Afshar, S.; Rostami, A.; Rashedi, S.; Bahrami, S.H. Fabrication and characterization of chitosan-polycaprolactone core-shell nanofibers containing tetracycline hydrochloride. Colloid. Surf. A 2022, 636, 128163. [Google Scholar] [CrossRef]
- Feng, X.C.; Hao, J.S. Identifying new pathways and targets for wound healing and therapeutics from natural sources. Curr. Drug Deliv. 2021, 18, 1064–1084. [Google Scholar] [CrossRef]
- Ji, Y.; Song, W.; Xu, L.; Yu, D.-G.; Annie-Bligh, S.W. A review on electrospun poly(amino acid) nano-fibers and their applications of hemostasis and wound healing. Biomolecules 2022, 12, 794. [Google Scholar] [CrossRef]
- Guidotti, G.; Soccio, M.; Bondi, E.; Posati, T.; Sotgiu, G.; Zamboni, R.; Torreggiani, A.; Corticelli, F.; Lotti, N.; Aluigi, A. Effects of the blending ratio on the design of keratin/poly(butylene succinate) nanofibers for drug delivery applications. Biomolecules 2021, 11, 1194. [Google Scholar] [CrossRef]
- Ziyadi, H.; Baghali, M.; Bagherianfar, M.; Mehrali, F.; Faridi-Majidi, R. An investigation of factors affecting the electrospinning of poly (vinyl alcohol)/kefiran composite nanofibers. Adv. Compos. Hybrid Mater. 2021, 4, 768–779. [Google Scholar] [CrossRef]
- Zhang, C.; Feng, F.; Zhang, H. Emulsion electrospinning: Fundamentals, food applications and prospects. Trends Food Sci.Tech. 2018, 80, 175–186. [Google Scholar] [CrossRef]
- Li, J.K.; Guan, S.M.; Su, J.J.; Liang, J.H.; Cui, L.L.; Zhang, K. The development of hyaluronic acids used for skin tissue regeneration. Curr. Drug Deliv. 2020, 18, 836–846. [Google Scholar] [CrossRef] [PubMed]
- Szabo, E.; Zahonyi, P.; Brecska, D.; Galata, D.L.; Meszaros, L.A.; Madarasz, L.; Csorba, K.; Vass, P.; Hirsch, E.; Szafraniec-Szczesny, J.; et al. Comparison of amorphous solid dispersions of spironolactone prepared by spray drying and electrospinning: The influence of the preparation method on the dissolution properties. Mol. Pharm. 2021, 18, 317–327. [Google Scholar] [CrossRef] [PubMed]
- Abdullah, M.F.; Andriyana, A.; Muhamad, F.; Ang, B.C. Effect of core-to-shell flowrate ratio on morphology, crystallinity, mechanical properties and wettability of poly(lactic acid) fibers prepared via modified coaxial electrospinning. Polymer 2021, 237, 124378. [Google Scholar] [CrossRef]
- Fusaro, L.; Gualandi, C.; Antonioli, D.; Soccio, M.; Liguori, A.; Laus, M.; Lotti, N.; Boccafoschi, F.; Focarete, M.L. Elastomeric electrospun scaffolds of a biodegradable aliphatic copolyester containing PEG-like sequences for dynamic culture of human endothelial cells. Biomolecules 2020, 10, 1620. [Google Scholar] [CrossRef]
- Torkamani, A.E.; Syahariza, Z.A.; Norziah, M.H.; Wan, A.K.M.; Juliano, P. Encapsulation of polyphenolic antioxidants obtained from Momordica charantia fruit within zein/gelatin shell core fibers via coaxial electrospinning. Food Biosci. 2018, 21, 60–71. [Google Scholar] [CrossRef]
- Ye, P.W.; Wei, S.Y.; Luo, C.H.; Wang, Q.R.; Li, A.Z.; Wei, F.H. Long-term effect against methicillin-resistant staphylococcus aureus of emodin released from coaxial electrospinning nanofiber membranes with a biphasic profile. Biomolecules 2020, 10, 362. [Google Scholar] [CrossRef]
- Niu, B.; Zhan, L.; Shao, P.; Xiang, N.; Sun, P.; Chen, H.; Gao, H. Electrospinning of zein-ethyl cellulose hybrid nanofibers with improved water resistance for food preservation. Int. J. Biol. Macromol. 2020, 142, 592–599. [Google Scholar] [CrossRef]
- Moreno, M.A.; Orqueda, M.E.; Gómez-Mascaraque, L.G.; Isla, M.I.; López-Rubio, A. Crosslinked electrospun zein-based food packaging coatings containing bioactive chilto fruit extracts. Food Hydrocolloid. 2019, 95, 496–505. [Google Scholar] [CrossRef]
- Zhou, S.; Hu, C.; Zhao, G.; Liu, L.; Sheen, S.; Yam, K.L. A novel gaseous chlorine dioxide generating method utilizing carbon dioxide and moisture respired from tomato for Salmonella inactivation. Food Control. 2018, 89, 54–61. [Google Scholar] [CrossRef]
- Abhirami, P.; Modupalli, N.; Natarajan, V. Novel postharvest intervention using rice bran wax edible coating for shelf-life enhancement of Solanum lycopersicum fruit. J. Food Process Pres. 2020, 44, 14989. [Google Scholar] [CrossRef]
- Lu, S.; Tao, J.; Liu, X.; Wen, Z. Baicalin-liposomes loaded polyvinyl alcohol-chitosan electrospinning nanofibrous films: Characterization, antibacterial properties and preservation effects on mushrooms. Food Chem. 2022, 371, 131372. [Google Scholar] [CrossRef] [PubMed]
- Barani, H.; Haseloer, A.; Mathur, S.; Klein, A. Sustained release of a thiosemicarbazone from antibacterial electrospun poly(lactic-co-glycolic acid) fiber mats. Polym. Advan. Technol. 2020, 31, 3182–3193. [Google Scholar] [CrossRef]
- Chen, W.; Zhao, P.; Yang, Y.Y.; Yu, D.G. Electrospun beads-on-the-string nanoproducts: Preparation and drug delivery application. Curr. Drug Deliv. 2022, 19, 1–13. [Google Scholar] [CrossRef] [PubMed]
- Casanova, M.R.; Reis, R.L.; Martins, A.; Neves, N.M. Stimulation of neurite outgrowth using autologous NGF bound at the surface of a fibrous substrate. Biomolecules 2022, 12, 25. [Google Scholar] [CrossRef] [PubMed]
- Salevic, A.; Prieto, C.; Cabedo, L.; Nedovic, V.; Lagaron, J.M. Physicochemical, antioxidant and antimicrobial properties of electrospun poly(epsilon-caprolactone) films containing a solid dispersion of sage (salvia officinalis L.) extract. Nanomaterials 2019, 9, 270. [Google Scholar] [CrossRef]
- Ibrahim, S.; Elsayed, H.; Hasnein, M. Biodegradable, antimicrobial and antioxidant biofilm for active packaging based on extracted gelatin and lignocelluloses biowastes. J. Polym. Environ. 2021, 29, 472–482. [Google Scholar] [CrossRef]
- El-Naggar, M.E.; Hasanin, M.; Hashem, A.H. Eco-Friendly synthesis of superhydrophobic antimicrobial film based on cellulose acetate/polycaprolactone loaded with the green biosynthesized copper nanoparticles for food packaging application. J. Polym. Environ. 2021, 30, 1820–1832. [Google Scholar] [CrossRef]
- Ibrahim, S.; El Saied, H.; Hasanin, M. Active paper packaging material based on antimicrobial conjugated nano-polymer/amino acid as edible coating. J. King Saud Univ. Sci. 2019, 31, 1095–1102. [Google Scholar] [CrossRef]
- Hasanin, M.S.; Emam, M.; Soliman, M.M.H.; Latif, R.R.A.; Salem, M.M.M.; Raey, M.A.E.; Eisa, W.H. Green silver nanoparticles based on Lavandula coronopifolia aerial parts extract against mycotic mastitis in cattle. Biocatal. Agric. Biotechnol. 2022, 42, 102350. [Google Scholar] [CrossRef]
- Elsayed, H.; Hasanin, M.; Rehan, M. Enhancement of multifunctional properties of leather surface decorated with silver nanoparticles (Ag NPs). J. Mol. Struct. 2021, 1234, 130130. [Google Scholar] [CrossRef]
- Hasanin, M.; Elbahnasawy, M.A.; Shehabeldine, A.M.; Hashem, A.H. Ecofriendly preparation of silver nanoparticles-based nanocomposite stabilized by polysaccharides with antibacterial, antifungal and antiviral activities. Biometals 2021, 34, 1313–1328. [Google Scholar] [CrossRef] [PubMed]
- da Costa de Quadros, C.; Lima, K.O.; Bueno, C.H.L.; dos Santos Fogaça, F.H.; Rocha, M.; Prentice, C. Effect of the edible coating with protein hydrolysate on cherry tomatoes shelf life. J. Food Process Pres. 2020, 44, 14760. [Google Scholar] [CrossRef]
- Chen, H.; Zhong, Q. Antibacterial activity of acidified sodium benzoate against Escherichia coli O157:H7, Salmonella enterica, and Listeria monocytogenes in tryptic soy broth and on cherry tomatoes. Int. J. Food Microbiol. 2018, 274, 38–44. [Google Scholar] [CrossRef] [PubMed]
- Mustapha, A.T.; Zhou, C. Novel assisted/unassisted ultrasound treatment: Effect on respiration rate, ethylene production, enzymes activity, volatile composition, and odor of cherry tomato. LWT-Food Sci. Technol. 2021, 149, 111779. [Google Scholar] [CrossRef]
- Liu, H.; Jiang, W.; Yang, Z.; Chen, X.; Yu, D.-G.; Shao, J. Hybrid films prepared from a combination of electrospinning and casting for offering a dual-phase drug release. Polymers 2022, 14, 2132. [Google Scholar] [CrossRef] [PubMed]
- Xu, H.; Zhang, F.; Wang, M.; Lv, H.; Yu, D.G.; Liu, X.; Shen, H. Electrospun hierarchical structural films for effective wound healing. Biomater. Adv. 2022, 136, 212795. [Google Scholar] [CrossRef] [PubMed]
- Du, Y.; Zhang, X.; Liu, P.; Yu, D.G.; Ge, R. Electrospun nanofibers-based glucose sensors for glucose detection. Front. Chem. 2022, 10, 944428. [Google Scholar] [CrossRef]
- Zhang, Y.; Kim, I.; Lu, Y.; Xu, Y.; Yu, D.G.; Song, W. Intelligent poly(l-histidine)-based nanovehicles for controlled drug delivery. J. Control. Release 2022, 349, 963–982. [Google Scholar] [CrossRef]
- Zhang, L.; He, G.; Yu, Y.; Zhang, Y.; Li, X.; Wang, S. Design of Biocompatible Chitosan/Polyaniline/Laponite Hydrogel with Photothermal Conversion Capability. Biomolecules 2022, 12, 1089. [Google Scholar] [CrossRef]

| Fiber No. | Electro- Spinning a | Applied Voltage (kV) | Core Fluid b | Sheath Fluid c | Product | ||||
|---|---|---|---|---|---|---|---|---|---|
| Polymer | Functional Ingredients | Flow Rate (mL/h) | Polymer | Functional Ingredients | Flow Rate (mL/h) | ||||
| F1 | Single-fluid | 5.5 | PEO | - | 0.8 | - | - | - | Fibers |
| F2 | Coaxial | 6.0 | PEO | - | 0.6 | Zein | - | 0.3 | Fibers |
| F3 | Single-fluid | 17 | - | - | - | Zein | AgNPs | 0.2 | Beads-on-a-string |
| F4 | Coaxial | 7.0 | PEO | - | 0.6 | Zein | AgNPs | 0.3 | Fibers |
| F5 | 7.0 | PEO | RE | 0.6 | Zein | AgNPs | 0.3 | ||
| F6 | 7.0 | PEO | RE | 0.6 | Zein | AgNPs + RE | 0.3 | ||
| Sample | Parallel Group Number | Bacterial Content (CFU × 106) | Sample Mass (g) | Bacterial Content per Mass (CFU/g × 105) |
|---|---|---|---|---|
| Unpacked | 1-1 | 2.2 | 11.32 | 1.9435 |
| 1-2 | 2.6 | 8.09 | 3.2138 | |
| 1-3 | 3.4 | 7.92 | 4.2929 | |
| Mean value | 3.1501 ± 1.1760 | |||
| F4 | 2-1 | 15 | 11.40 | 13.1579 |
| 2-2 | 3.5 | 10.12 | 3.4585 | |
| 2-3 | 1.3 | 10.40 | 1.2500 | |
| Mean value | 5.9555 ± 6.3345 | |||
| F5 | 3-1 | 0.4 | 8.46 | 0.4728 |
| 3-2 | 2.0 | 6.98 | 2.8653 | |
| 3-3 | 1.8 | 9.61 | 1.8730 | |
| Mean value | 1.7371 ± 1.2020 | |||
| F6 | 4-1 | 1.8 | 9.46 | 1.9027 |
| 4-2 | 1.6 | 10.13 | 1.5795 | |
| 4-3 | 1.3 | 9.97 | 1.3039 | |
| Mean value | 1.5954 ± 0.2997 |
Publisher’s Note: MDPI stays neutral with regard to jurisdictional claims in published maps and institutional affiliations. |
© 2022 by the authors. Licensee MDPI, Basel, Switzerland. This article is an open access article distributed under the terms and conditions of the Creative Commons Attribution (CC BY) license (https://creativecommons.org/licenses/by/4.0/).
Share and Cite
Jiang, W.; Zhao, P.; Song, W.; Wang, M.; Yu, D.-G. Electrospun Zein/Polyoxyethylene Core-Sheath Ultrathin Fibers and Their Antibacterial Food Packaging Applications. Biomolecules 2022, 12, 1110. https://doi.org/10.3390/biom12081110
Jiang W, Zhao P, Song W, Wang M, Yu D-G. Electrospun Zein/Polyoxyethylene Core-Sheath Ultrathin Fibers and Their Antibacterial Food Packaging Applications. Biomolecules. 2022; 12(8):1110. https://doi.org/10.3390/biom12081110
Chicago/Turabian StyleJiang, Wenlai, Ping Zhao, Wenliang Song, Menglong Wang, and Deng-Guang Yu. 2022. "Electrospun Zein/Polyoxyethylene Core-Sheath Ultrathin Fibers and Their Antibacterial Food Packaging Applications" Biomolecules 12, no. 8: 1110. https://doi.org/10.3390/biom12081110
APA StyleJiang, W., Zhao, P., Song, W., Wang, M., & Yu, D.-G. (2022). Electrospun Zein/Polyoxyethylene Core-Sheath Ultrathin Fibers and Their Antibacterial Food Packaging Applications. Biomolecules, 12(8), 1110. https://doi.org/10.3390/biom12081110

